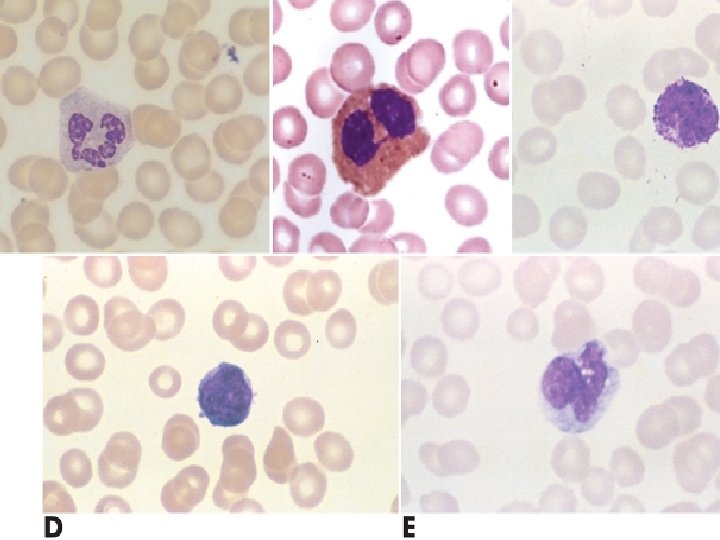

3028463bb20f63d51ae69bfeebac53fc.ppt
- Количество слайдов: 142

Denver School of Nursing Human Pathophysiology Bio 206 / 308 – ch 19 & 20 Hemo PATH

Hematology Chapter 19 & 20 Image Source: http: //www. beliefnet. com

Hematology Source: Huether, Mc. Cance Understanding Pathophysiology 4 th Ed. 2008

Components of the Hematologic System Composition of blood 90% water and 10% solutes 6 quarts (5. 5 L = “about 6 liters”) Plasma ▪ 55% to 60% of the blood volume ▪ Organic and inorganic elements

Components of the Hematologic System Chief Function Delivery of substances needed for cellular metabolism Removal of wastes Defense against microorganisms and injury Maintenance of acid-base balance

Components of the Hematologic System Composition of blood Plasma proteins ▪ Albumins ▪ Function as carriers and control the plasma oncotic pressure ▪ Globulins ▪ Carrier proteins and immunoglobulins (antibodies) ▪ Clotting factors ▪ Mainly fibrinogen

Components of the Hematologic System Composition of blood Cellular components ▪ Erythrocytes ▪ ▪ Most abundant cell in the body Responsible for tissue oxygenation Biconcavity and reversible deformity 120 -day life cycle


Composition of Blood Cellular components Leukocytes (white blood cells) ▪ Defend the body against infection and remove debris ▪ Granulocytes ▪ Membrane-bound granules in their cytoplasm ▪ The granules contain enzymes capable of destroying microorganisms ▪ Inflammatory and immune functions ▪ Capable of ameboid movement (diapedesis)

Composition of Blood After all of your immuno studies what blood cells would you consider to be granulocytes? ?

Composition of Blood Granulocytes Neutrophils ▪ Polymorphonuclear neutrophil (PMN) ▪ Phagocytes in early inflammation Eosinophils ▪ Eosinophils ingest antigen-antibody complexes ▪ Induced by Ig. E hypersensitivity ▪ Increase in parasitic infections

Composition of Blood Granulocytes- basophils Mast cells ▪ Central cell in inflammation ▪ Found in vascularized connective tissue Basophils ▪ Structurally and functionally similar to mast cells

Composition of Blood Agranulocytes Monocytes and macrophages make up the mononuclear phagocyte system (MPS) Monocytes Macrophages Lymphocytes-T & B Natural killer (NK) cells

Composition of Blood Platelets Disk-shaped cytoplasmic fragments Essential for blood coagulation and control of bleeding Thrombopoietin ▪ Main regulator of platelets


Lymphoid Organs Spleen Largest secondary lymphoid organ Splenic pulp ▪ Masses of lymphoid tissue containing macrophages and lymphoid tissue Venous sinuses ▪ Phagocytosis of old, damaged, and dead blood cells ▪ Blood storage

Lymphoid Organs Lymph nodes Part of the immune and hematologic systems ▪ Facilitates maturation of lymphocytes ▪ Transports lymphatic fluid back to the circulation ▪ Cleanses the lymphatic fluid of microorganisms and foreign particles

Lymphoid Organs

Mononuclear Phagocyte System (MPS) The MPS consists of a line of cells that originate in the bone marrow, are transported into the bloodstream, differentiate into monocytes, and settle in the tissues as mature macrophages Cells of the MPS ingest and destroy microorganisms and foreign material The MPS is mostly the liver and spleen

Hematopoiesis is the process of blood cell production Two stages Mitosis ▪ Mitosis stops before the cell enters the peripheral blood Maturation and differentiation

Hematopoiesis Stem cell system Pluripotent stem cells Colony-stimulating factors Bone marrow Also called myeloid tissue Red and yellow bone marrow Adult active bone marrow ▪ Pelvic bones, vertebrae, cranium and mandible, sternum and ribs, humerus, and femur

Hematology – Which Filter is this? ? Source: Huether, Mc. Cance Understanding Pathophysiology 4 th Ed. 2008

Source: Huether, Mc. Cance Understanding Pathophysiology 4 th Ed. 2008


Erythropoiesis Erythrocytes are derived from erythroblasts (normoblasts) Maturation is stimulated by erythropoietin

Erythropoiesis Sequence Uncommitted pluripotent stem cell, committed proerythroblast, normoblast, basophilic normoblast, polychromatophilic normoblast, orthochromic normoblast, reticulocyte (nucleus is lost), erythrocyte In each step the quantity of hemoglobin increases and the nucleus decreases in size

Erythropoiesis


Regulation of Erythropoiesis Numbers of circulating red cells in healthy individuals remain constant The peritubular cells of the kidney produce erythropoietin Hypoxia stimulates the production and release of erythropoietin

Regulation of Erythropoiesis Erythropoietin causes an increase in red cell production and release from bone marrow

Red Blood Cells Source: googleimages. com

Hemoglobin Synthesis Oxygen-carrying protein of the erythrocyte A single erythrocyte contains as many as 300 million hemoglobin molecules Two pairs of polypeptide chains Globulins

Hemoglobin Synthesis Four colorful iron-protoporphyrin complexes Adult hemoglobin Two alpha chains and two beta chains

Hemoglobin Synthesis Source: Huether: Understanding Pathophysiology, 4 th Edition, 2008

Hemoglobin Source: Huether: Understanding Pathophysiology, 4 th Edition, 2008

Hemoglobin Synthesis Nutritional requirements Building blocks ▪ Proteins ▪ Amino acids ▪ Vitamins B 12, B 6, B 2, E, and C; folic acid; pantothenic acid; and niacin ▪ Minerals ▪ Iron and copper ▪ Folate

Hemoglobin Synthesis Iron cycle Total body iron is bound to heme or stored bound to ferritin or hemosiderin mononuclear phagocytes and hepatic parenchymal cells Less than 1 mg per day is lost in the urine, sweat, epithelial cells, or from the gut Transferrin Apotransferrin-w/o Oxygen

Iron Cycle Source: Huether: Understanding Pathophysiology, 4 th Edition, 2008

Normal Destruction of Senescent Erythrocytes Aged red cells are sequestered and destroyed by macrophages of the MPS, primarily in the spleen The liver takes over if the spleen is absent Globin chains are broken down into amino acids Role of B 12 & Folate in RBC life span

Normal Destruction of Senescent Erythrocytes Porphyrin is reduced to bilirubin, transported to the liver, and secreted in the bile

Hematology Path What is the most common cause of hypocalcemia? What is the largest protein molecule in blood? Source: Robbins Pathologic Basis of Disease 8 th Edition 2010

Hematology – Iron Cycle Source: Huether, Mc. Cance Understanding Pathophysiology 4 th Ed. 2008 (Fig 19 -13)

Hematology – Metabolism of Bilirubin Source: Huether, Mc. Cance Understanding Pathophysiology 4 th Ed. 2008 (Fig 19 -14)

Development of Leukocytes arise from stem cells in the bone marrow Granulocytes mature in the bone marrow Agranulocytes and monocytes are released into the bloodstream before they fully mature

Development of Leukocytes Growth factors and colony-simulating factors encourage production and maturation of leukocytes

White Blood Cells

Development of Platelets Endomitosis The megakaryocyte undergoes the nuclear phase of cell division but fails to undergo cytokinesis The megakaryocyte expands due to the doubling of the DNA and breaks up into fragments

Development of Platelets Platelet levels are maintained by thrombopoietin and IL-11 Platelets circulate for 10 days before losing their functional capacity

Hemostasis means arrest of bleeding Requirements Platelets Clotting factors Blood flow and shear forces Endothelial cells Fibrinolysis

Hemostasis Virchow's Triad - Causes of Thrombosis 1) Changes in the blood vessel wall 2) Changes in blood flow 3) Changes in blood composition

What does that thrombo really do? 1. Vasospasm a)Plug b)Activate coagulation cascade 2. Initiate repair

Platelets

Hemostasis

Hemostasis

Hemostasis Platelet plug formation Activation – Calcium essential for platelet activation Adhesion ▪ von Willebrand factor (v. WF) Activation (Again) Aggregation Secretion granules release…

Hemostasis Platelet secretion: Alpha granules have P-selectins on their membranes and contain fibrinogen, fibronectin, factors V and VIII, platelet factor 4, platelet-derived growth factor, and TGFβ. Delta granules, contain adenine nucleotides ADP and ATP, ionized calcium, histamine, seratonin, and epinephrine.

Hematology – Hemostasis What are the 4 most important players of Hemostasis (A&P Review)? ?

Hematology – Hemostasis What are the 4 most important players of Hemostasis (A&P Review)? ? Thrombinogen Thrombin Fibrinogen Fibrin

Hemostasis & the Clotting Cascade

Hemostasis & the Clotting Cascade

Hematology – Hemostasis

Hemostasis Intrinsic pathway ▪ Activated when factor XII contacts subendothelial substances exposed by vascular injury Extrinsic pathway ▪ Activated when tissue factor (TF) (tissue thromboplastin) is released by damaged endothelial cells

Coagulation Cascade

Control of Hemostatic Mechanisms Clot retraction Fibrin strands shorten; become denser and stronger to approximate the edges of the injured vessel and site of injury Facilitated by large numbers of platelets within the clot and actin-like contractile proteins in the platelets

The Clotting Cascade Extrinsic Pathway Intrinsic Pathway Tissue/Cell Defect Surface Contact Collagen FXII activator F XIIa F XI F VIIa Ca 2+ F VII F XIa F IX Ca 2+ F VIIIa Platelet Factor 3 Factor F X F III (Tissue Thromboplastin) F IXa Ca 2+ Factor F Xa F Va Prothrombin I F XIIIa Crosslinked Fibrin Meshwork Ca 2+ Factor F X FV Thrombin F XIII Fibrin polymers Fibrin monomers Fibrinogen

Blood Clotting-sticky platlets

Blood Clotting-plug

Blood Clotting-fibrin net

Thrombosis

Control of Hemostatic Mechanisms Lysis of blood clots Fibrinolytic system ▪ Plasminogen and plasmin ▪ Fibrin degradation products ▪ D-dimers

Fibrinolytic

The Fibrinolytic System Clotting Cascade Fibrinogen Fibrin degradation products Fibrin-clot Plasminogen T-PA F XIIa HMWK Kallikrein Urokinase Streptokinase Plasmin

Evaluation of the Hematologic System Tests of bone marrow function Bone marrow aspiration Bone marrow biopsy Measurement of bone marrow iron stores Differential cell count Blood tests Large variety of tests

Pediatrics and the Hematologic System Blood cell counts increase above adult levels at birth Trauma of birth and cutting the umbilical cord The hypoxic intrauterine environment stimulates erythropoietin production Results in polycythemia

Pediatrics and the Hematologic System Children tend to have more atypical lymphocytes as a result of frequent viral infections

Hematology – What is Anemia? ? Source: Huether, Mc. Cance Understanding Pathophysiology 4 th Ed. 2008

Hematology – What is Anemia? ? Source: Huether, Mc. Cance Understanding Pathophysiology 4 th Ed. 2008

Hematology – Progression of Anemia Source: Huether, Mc. Cance Understanding Pathophysiology 4 th Ed. 2008

Anemia Classifications Etiology Morphology ▪ Based on MCV, MCH, and MCHC values ▪ Size ▪ Identified by terms that end in “-CYTIC ▪ Macrocytic, microcytic, normocytic ▪ Hemoglobin content ▪ Identified by terms that end in “-CHROMIC ▪ Normochromic and hypochromic

Anemia Anisocytosis Red cells are present in various sizes Poikilocytosis Red cells are present in various shapes

Anemia Physiologic manifestation Reduced oxygen-carrying capacity Variable symptoms based on severity and the ability for the body to compensate Classic anemia symptoms Fatigue, weakness, dyspnea, and pallor

Hematology – Symptoms of Iron Deficiency Does anyone know what this condition of “spoon nails” is called? Source: Huether, Mc. Cance Understanding Pathophysiology 4 th Ed. 2008

Hematology – Symptoms of Iron Deficiency Koilonychia = spooned nails Source: Huether, Mc. Cance Understanding Pathophysiology 4 th Ed. 2008

Macrocytic-Normochromic Anemias Also termed megaloblastic anemias Characterized by defective DNA synthesis Caused by deficiencies in vitamin B 12 or folate ▪ Coenzymes for nuclear maturation and the DNA synthesis pathway

Macrocytic-Normochromic Anemias Pernicious anemia Caused by a lack of intrinsic factor from the gastric parietal cells Required for vitamin B 12 absorption Results in vitamin B 12 deficiency

Macrocytic-Normochromic Anemias Pernicious anemia Typical anemia symptoms Neurologic manifestations ▪ Nerve demyelination ▪ Absence of intrinsic factor Others ▪ Loss of appetite, abdominal pain, beefy red tongue (atrophic glossitis), icterus, and splenic enlargement

Macrocytic-Normochromic Anemias Pernicious anemia Treatment ▪ Parenteral or high oral doses of vitamin B 12

Source: Lippincott Pathophysiology, Williams & Wilkins 2003

Macrocytic-Normochromic Anemias Folate deficiency anemia Absorption of folate occurs in the upper small intestine Not dependent on any other factor Similar symptoms to pernicious anemia except neurologic manifestations generally not seen Treatment requires daily oral administration of folate


Microcytic-Hypochromic Anemias Characterized by red cells that are abnormally small and contain reduced amounts of hemoglobin Related to: Disorders of iron metabolism Disorders of porphyrin and heme synthesis Disorders of globin synthesis

Source: Lippincott Pathophysiology, Williams & Wilkins 2003

Microcytic-Hypochromic Anemias Iron deficiency anemia Most common type of anemia worldwide Nutritional iron deficiency Metabolic or functional deficiency Progression of iron deficiency causes: ▪ Brittle, thin, coarsely ridged, and spoon-shaped nails ▪ A red, sore, and painful tongue

Source: Lippincott Pathophysiology, Williams & Wilkins 2003

Microcytic-Hypochromic Anemias Sideroblastic anemia Group of disorders characterized by anemia Altered mitochondrial metabolism causing ineffective iron uptake and resulting in dysfunctional hemoglobin synthesis Ringed sideroblasts within the bone marrow are diagnostic ▪ Sideroblasts are erythroblasts that contain iron granules that have not been synthesized into hemoglobin

Microcytic-Hypochromic Anemias Sideroblastic anemia Dimorphism Myelodysplastic syndrome Erythropoietic hemochromatosis Mito becomes not so mighty…

Normocytic-Normochromic Anemias Characterized by red cells that are relatively normal in size and hemoglobin content but insufficient in number

Normocytic-Normochromic Anemias Aplastic anemia Pancytopenia Pure red cell aplasia Fanconi anemia Posthemorrhagic anemia Acute blood loss from the vascular space

Normocytic-Normochromic Anemias Hemolytic anemia Accelerated destruction of red blood cells Autoimmune hemolytic anemias Immunohemolytic anemia Warm antibody immunohemolytic anemia Drug-induced hemolytic anemia Cold agglutinin immunohemolytic anemia Cold hemolysin hemolytic anemia

Normocytic-Normochromic Anemias Sickle cell anemia Anemia of chronic inflammation Mild to moderate anemia seen in: ▪ AIDS, rheumatoid arthritis, lupus erythematosus, hepatitis, renal failure, and malignancies


Source: Lippincott Pathophysiology, Williams & Wilkins 2003

Normocytic-Normochromic Anemias Anemia of chronic inflammation Pathologic mechanisms ▪ Decreased erythrocyte life span ▪ Ineffective bone marrow response to erythropoietin ▪ Altered iron metabolism

Myeloproliferative RBC Disorders Polycythemia Overproduction of red blood cells Relative polycythemia Result of dehydration Fluid loss results in relative increases of red cell counts and Hgb and Hct values

Polycythemia Absolute polycythemia Primary absolute ▪ Abnormality of stem cells in the bone marrow ▪ Polycythemia vera (PV) Secondary absolute ▪ Increase in erythropoietin as a normal response to chronic hypoxia or an inappropriate response to erythropoietin-secreting tumors

Quantitative Alterations of Leukocytes Leukocytosis is a normal protective physiologic response to physiologic stressors Leukopenia is not normal and not beneficial A low white count predisposes a patient to infections

Infectious Mononucleosis Acute, self-limiting infection of Blymphocytes transmitted by saliva through personal contact Commonly caused by: Epstein-Barr virus (EBV)— 85% B cells have an EBV receptor site Others viral agents resembling IM ▪ Cytomegalovirus (CMV), hepatitis, influenza, HIV

Infectious Mononucleosis Symptoms: fever, sore throat, swollen cervical lymph nodes, increased lymphocyte count, and atypical (activated) lymphocytes Serious complications are infrequent (<5%) Splenic rupture is the most common cause of death

Leukemias Malignant disorder of the blood and blood-forming organs Excessive accumulation of leukemic cells Acute leukemia Presence of undifferentiated or immature cells, usually blast cells Chronic leukemia Predominant cell is mature but does not function normally

Leukemias Acute lymphocytic leukemia (ALL) Acute myelogenous leukemia (AML) Chronic myelogenous leukemia (CML) Chronic lymphocytic leukemia (CLL)

Leukemias

Leukemias Signs and symptoms of leukemia Anemia, bleeding purpura, petechiae, ecchymosis, thrombosis, hemorrhage, DIC, infection, weight loss, bone pain, elevated uric acid, and liver, spleen, and lymph node enlargement

Philadelphia Chromosome chronic myelogenous leukemia (CML)

Philadelphia Chromosome chronic myelogenous leukemia (CML) CML accounts for about 15% of all leukemia cases in the United States, 4, 570 new cases diagnosed in 2007. The Leukemia & Lymphoma Society estimates that over 21, 500 people are living with CML. It can occur at any age, but most often occurs in people over age 50. Only 10% of people diagnosed with CML are under the age of 20. Source: NIH. gov

Lymphadenopathy Enlarged lymph nodes that become palpable and tender Local lymphadenopathy Drainage of an inflammatory lesion located near the enlarged node General lymphadenopathy Occurs in the presence of malignant or nonmalignant disease

Lymphadenopathy

Malignant Lymphomas Malignant transformation of a lymphocyte and proliferation of lymphocytes, histiocytes, their precursors, and derivatives in lymphoid tissues Two major categories Ø Hodgkin lymphoma Ø Non-Hodgkin lymphomas

Hematology – Lymphoma Hodgkin Lymphoma Characterized by: ▪ 1) Progression from one group of lymph nodes to another ▪ 2) The development of systemic symptoms ▪ 3) Presence of Reed-Sternberg (RS) cells Non-Hodgkin Lymphoma Characterized by two different types: ▪ 1) B-Cell Neoplasms – Includes myelomas orginating from B cells at multiple stages of differentiation. ▪ 2) T & NK cell Neoplasms – originating from T and NK cells. ▪ Unlike HL both types lack RS cells and have different systemic symptoms Source: Huether, Mc. Cance Understanding Pathophysiology 4 th Ed. 2008

Hodgkin Lymphoma Characterized by the presence of Reed. Sternberg cells in the lymph nodes Reed-Sternberg cells are necessary for diagnosis, but they are not specific to Hodgkin lymphoma Classical Hodgkin lymphoma Nodular lymphocyte predominant Hodgkin lymphoma

Hodgkin Lymphoma

Hodgkin Lymphoma Physical findings Adenopathy, mediastinal mass, splenomegaly, and abdominal mass Symptoms Fever, weight loss, night sweats, pruritus Laboratory findings Thrombocytosis, leukocytosis, eosinophilia, elevated ESR, and elevated alkaline phosphatase Paraneoplastic syndromes

Hematology – Burkitt Lymphoma There are two broad types of Burkitt’s lymphoma – the sporadic and the endemic varieties. There is a very high incidence of this disease in equatorial Africa, and disease in this region is called endemic Burkitt’s lymphoma. Disease in other regions of the world is much less common, and is called sporadic Burkitt’s lymphoma. Though they are the same disease, the two forms are different in many ways. Source: Huether, Mc. Cance Understanding Pathophysiology 4 th Ed. 2008 + http: //lymphoma. about. com

Disorders of Platelets Thrombocytopenia Platelet count <150, 000/mm 3 ▪ <50, 000/mm 3—hemorrhage from minor trauma ▪ <15, 000/mm 3—spontaneous bleeding ▪ <10, 000/mm 3—severe bleeding

Disorders of Platelets Essential (primary) thrombocythemia Thrombocythemia is characterized by platelet counts >400, 000/mm 3 Myeloproliferative disorder of platelet precursor cells ▪ Megakaryocytes in the bone marrow are produced in excess Microvasculature thrombosis occurs

Alterations of Platelet Function Qualitative alterations in platelet function demonstrate an increased bleeding time in the presence of a normal platelet count Platelet function disorders result from platelet membrane glycoprotein and von Willebrand factor deficiencies

Alterations of Platelet Function Manifestations Petechiae, purpura, mucosal bleeding, gingival bleeding, and spontaneous bruising Disorders can be congenital or acquired

Alterations of Coagulation Vitamin K deficiency Vitamin K is necessary for synthesis and regulation of prothrombin, the prothrombin factors (II, VII, IX, X), and proteins C and S (anticoagulants) Liver disease causes a broad range of hemostasis disorders ▪ Defects in coagulation, fibrinolysis, and platelet number and function

Alterations in Coagulation Hemophilia A -1/5000 -sex linked : Xp 28 -loss of factor VIII -female : modest reduction…X inactivation (Lyon Hypothesis) Hemophilia B -loss of factor IX, Xp 27… disease

Alterations in Coagulation Intrinsic Pathway -initiated: negatively charged surface a. damaged endothelium b. surface contact with foreign substances c. PTT Extrinsic Pathway -initiated: activation tissue thromboplastin a. cell injury endothelium/others b. PT

Alterations in Coagulation PTT = Partial Thromboplastin Time The PTT test is used to investigate unexplained bleeding or clotting. Specific evaluation of the coagulation factors XII, XI, IX, VIII, X, V, II (prothrombin), and I (fibrinogen) as well as prekallikrein (PK) and high molecular weight kininogen (HK) PT = Prothrombin time PT evaluates hemostasis, the process that the body uses to form blood clots to help stop bleeding. A PT test evaluates the coagulation factors VII, X, V, II, and I (fibrinogen). INR (International Normalized Ratio) is also used for patients on what TX? ?

The Clotting Cascade Extrinsic Pathway Intrinsic Pathway Tissue/Cell Defect Surface Contact Collagen FXII activator F XIIa F XI F VIIa Ca 2+ F VII F XIa F IX Ca 2+ F VIIIa Platelet Factor 3 Factor F X F III (Tissue Thromboplastin) F IXa Ca 2+ Factor F Xa F Va Prothrombin I F XIIIa Crosslinked Fibrin Meshwork Ca 2+ Factor F X FV Thrombin F XIII Fibrin polymers Fibrin monomers Fibrinogen


Queen Victoria

Hematology – Hemophilia A – Genetic deficiency in Clotting factor VIII Hemophilia B – Genetic deficiency in Clotting factor IX (Christmas Disease) Transmission of A & B is via recessive X linked inheritance however 1/3 of cases occur due to spontaneous mutations. Incidence All forms of hemophilia are relatively rare. It affects ALL racial groups and is found worldwide. Estimated 10, 000 individuals with Hemophila in the UK Hemophilia A affects 1 in 5, 000 to 10, 000 males in the UK Hemophila B affects 1 in 30, 000 males in the UK Source: National Center for Biotechnology Information - http: //www. ncbi. nlm. nih. gov

Hematology – Hemostasis

Disseminated Intravascular Coagulation (DIC) Complex, acquired disorder in which “clotting and hemorrhage simultaneously occur” DIC is the result of increased protease activity in the blood caused by unregulated release of thrombin with subsequent fibrin formation and accelerated fibrinolysis

Disseminated Intravascular Coagulation (DIC) Endothelial damage is the primary initiator of DIC

Disseminated Intravascular Coagulation (DIC) By activating the fibrinolytic system (plasmin), the patient’s fibrin degradation product (FDP) and Ddimer levels will increase Because of the patient’s clinical state, the disorder has a high mortality rate Treatment is to remove the stimulus

Disseminated Intravascular Coagulation (DIC) Clinical signs and symptoms demonstrate wide variability Bleeding from venipuncture sites Bleeding from arterial lines Purpura, petechiae, and hematomas Symmetric cyanosis of the fingers and toes

And….

Done & Done
3028463bb20f63d51ae69bfeebac53fc.ppt